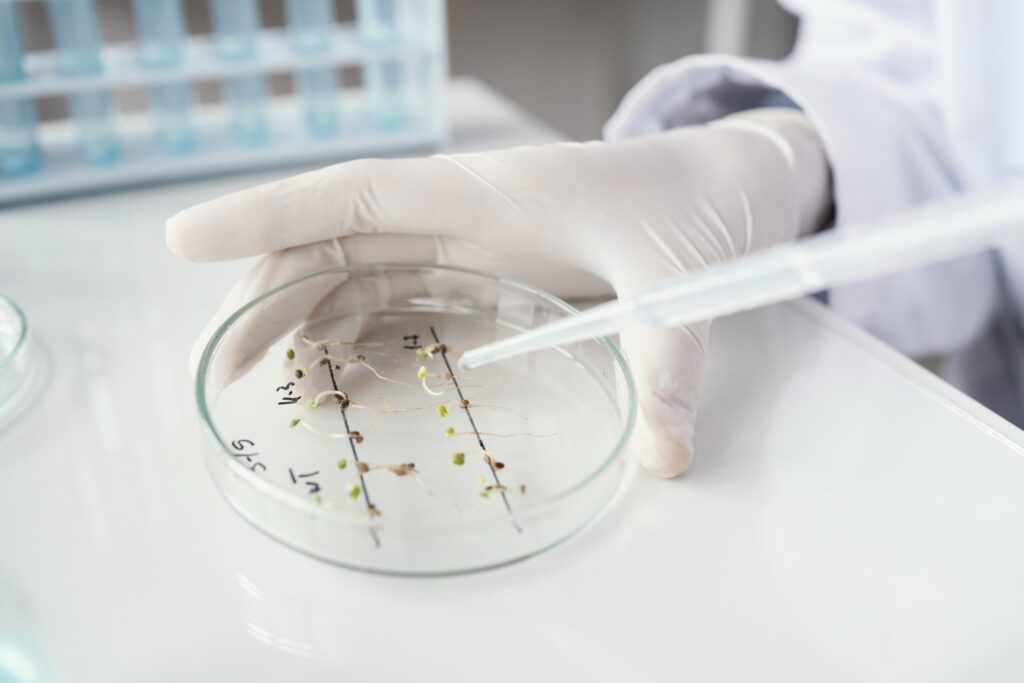

基因就像人體說明書,記載著重要的遺傳密碼。在近年越趨精準及個人化的癌症治療中,癌症基因檢測佔重要角色,有關技術的發展更是一日千里,基因排序目前已發展至第三代,有助在更高成本效益、更快的速度下,更全面地揭示出腫瘤細胞的基因特性,有助醫生制定個人化治療策略。

主持:今天的主題是「癌症基因檢測」。今天請到來自養和醫院臨床病理科及分子病理科主任馬紹鈞醫生,為大家講解一下相關知識。馬醫生,究竟基因是甚麼?
醫生:很多人以為基因很深奧,其實基因就是遺傳密碼的基本單位( gene),每個基因也會轉錄及轉譯為蛋白質,以控制細胞,甚至整個生物功能及調節其他基因活動。人類大約有三萬個基因,其實每個人的基因有約99%是相同的,而餘下的1%差異非常重要,就如指紋或身份證般,以分辨出每個人。
主持:甚麼是基因測試?
醫生:基因測試的目的是檢視基因是否存在異常,從而達致醫學診斷和治療等。基因測試所涵蓋範圍非常廣泛,主要可分為以下三大類:第一是針對先天遺傳基因異常,例如:香港較常見的地中海貧血症,可透過血液學測試或直接進行基因檢測作篩查與診斷;第二類是針對後天發生的基因變異,特別是與癌症和腫瘤相關的基因變異,這些變異並非遺傳而來,而是在腫瘤細胞中出現的後天變異;第三類則為與傳染病相關的基因檢測,例如:流感病毒或新冠病毒,這些檢測可透過分析病毒基因以判斷感染情況。
主持:為甚麼基因會發生變異?
醫生:其實基因變異的成因,很多時候也是不明,而且變異的形式眾多,當中包括基因突變,例如:遺傳密碼以「ATCG」組成,原本應該是「A」的位置可能變成「T」的話,即出現突變;第二類是基因擴大、拷貝或缺失,即特定基因有所增加或減少;第三類則是染色體的交換,例如兩個原本位於不同位置的基因「A」與「B」,因染色體交換而靠近,可能導致發病。
雖然醫學界對這些基因變異已有相當程度的理解,但實際發生的機制仍是不明。不過,部分已知的外在因素如輻射、高劑量化療或接觸某些化學物質,確實有可能引致基因變異。
主持:談到癌症基因檢測,哪類人士及甚麼時候應該考慮進行基因測試?
醫生:其實所有癌症也可以進行癌症基因檢查,但基因檢測其中一個重要作用,是配對合適的治療,因此醫生會視乎不同癌症的種類及其治療選擇而判斷是否進行基因檢測。舉例而言,肺癌、血癌、大腸癌、乳癌、淋巴癌,這些腫瘤的突變基因有不少都可作藥靶,讓醫生更清晰地對症下藥,因此一般會建議這類患者在剛確診階段便進行基因測試,以抓緊治療時機。

以在香港常見的肺癌為例,如患者的腫瘤帶有EGFR基因突變,醫生便可使用相應的標靶藥物包括EGFR抑制劑進行治療,效果較理想。這意味即使同樣是患上肺癌,每位病人的腫瘤基因特性也不盡相同,需要不同的治療方案。可見現時的基因檢測可以幫助癌症治療變成更個人化、精準化,讓每位病人都能夠獲得適合治療。
相反地,例如肝癌,即使找出基因突變,但現時臨床上未必能對應相關的標靶藥物,則未必需要在剛確診階段時便進行基因測試,須視乎個案再作決定。
另外,當病情發展至較後期、已擴散或治療一段時間後出現抗藥性,醫生或建議患者進行大規模的基因測試,希望可以幫助患者即使在癌症後期的階段,仍能嘗試找出可行的治療方法。

主持:基因檢測似乎發展得非常迅速,剛才提到的「精準醫療」,意思是能針對協助患者和醫生決定治療方式嗎?
醫生:現時基因檢測技術發展確實是一日千里,尤其是在病理化驗方面,以往檢驗癌症基因時,主要是從染色體層面觀察,以「螢光原位雜交」技術,觀察染色體變異;也會使用聚合酶鏈反應(PCR)等方法去檢查腫瘤是否有突變。
如今已經發展至基因排序技術,檢測腫瘤基因突變,其發展相當迅速,從最初的第一代基因排序技術,演進到第二代,甚至現在有第三代基因排序技術。因此在癌症基因檢測方面,相比以往我們能做的,現時已大有進步。
主持:基因檢測除了能應用於了解癌症特性,如果在身體狀況一切正常的情況下,基因檢測技術可否用於癌症篩查,做到及早發現?
醫生:其實以基因檢測及早發現癌症,現時仍然有一定難度,不過這個觀念非常正確,預防勝於治療。若能在尚未出現病徵的階段進行篩查,甚至在早期發現癌症,當然是有利,惟現階段仍待進一步研究,目前未能應用於臨床。不過在香港,成功例子就是透過檢測血液中的EB病毒(Epstein-Barr Virus)的基因,以進行鼻咽癌篩查,這方法在香港已經應用得相當成功。
至於其他癌症,例如肺癌、大腸癌、乳癌,的確仍有不少研究正在進行,但我相信將來會有機會,透過基因檢測以更早地發現癌症。

主持:基因檢測對病人而言,實際操作上會否很複雜?
醫生:對病人而言,其實操作上並不複雜;但對病理化驗的團隊而言,整個檢測過程是相對複雜的。例如是血癌個案,患者需要抽血或者抽取骨髓;淋巴瘤則需抽取淋巴組織;乳癌的話,需透過抽針活檢或手術進行組織切片,以最合適的方法檢測基因變化。
再以肺癌為例,在確診初期,可以先以基因排序檢測11個與肺癌相關的基因。以往使用的是第一代基因排序,方法雖然準確,但因其通量低(即難以一次過分析多個基因),所耗用的時間和成本會較高。現時,多採用第二代基因排序技術,這種方法通量高,可以一次過檢測十多個基因,並且能重複多次檢查,除了結果準確,更可以縮短檢測時間,合乎成本效益,一次過分析腫瘤基因突變,幫助醫生為病人選擇最合適的標靶藥物。
除了基因排序,同時也會進行其他輔助測試,如「螢光原位雜交」或「聚合酶鏈反應」等,以提升檢測的完整性與精確度。總括來說,目標就是在又快又準確的情況下,找出病人基因上的異常,讓醫生可以精準用藥。
主持:如果可以做到快、準、對症下藥,相信會大大減輕病人負擔,如大家有需要也應該主動向醫生了解是否適合接受基因檢測,好好掌握治療方向。馬醫生,多謝你今天的分享,我們下次再談,再見。
















